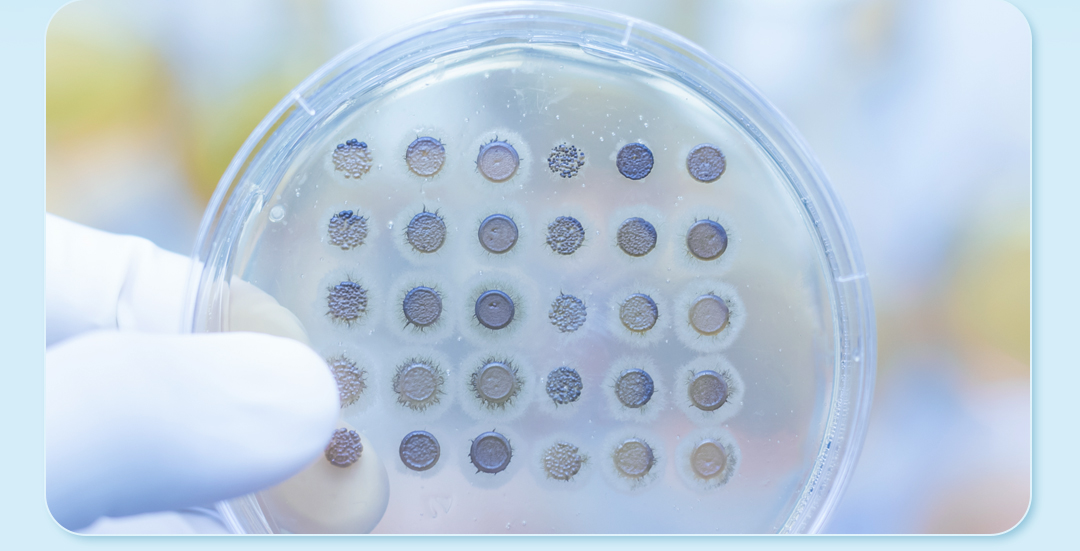

新闻资讯
以科技保证品质,服务完善产品

生物摇床是实验室常见的悬浮培养设备,应用于对温度、振荡频率有着较高要求的生物、细菌、细胞、组织等的培养及研究。应用并服务于疫苗生物制药企业、大学科研项目、疾病控制研究单位、第三方检测实验室等。
细胞培养需要适宜的生长环境和生长温度,需要选择合适的生物摇床进行辅助。那么下面简单分析一下细胞培养需要的环境和转数,选择适合的生物摇床。
CO2生物摇床:哺乳动物细胞、CHO细胞、293细胞、微藻
哺乳动物细胞培养:
易受机械力损伤,需低转速培养,5%CO2条件培养,建议转速:<200rpm。

通用生物摇床:细菌、真菌等微生物的培养
大肠杆菌培养:
生长迅速,高转速条件下不易被破坏,建议转速:200~250rpm。
真菌培养:
粘稠的培养基降低氧转移率,不利真菌生长,培养物不超过培养瓶容积的20%,建议转速:<200rpm。
昆虫细胞培养:
昆虫的真核细胞培养,昆虫多角体病毒可以高水平表达蛋白,其基因片段可以用来构建重组病毒以表达外源基因,生产某些药用蛋白。为保证安全性,大多使用昆虫病毒,首先要进行昆虫细胞培养,27-28℃,1-2天培养。建议转速:150rpm左右。

being生物摇床系列产品,专为悬浮培养设计理想培养环境:
红外(IR)传感器准确控制CO2气体浓度,90℃高温高湿灭菌提供安全培养环境,(BIOS系列及 BSIC系列特有);

制冷与制热双向温度控制功能,确保了温度控制更准确;
三偏心轴驱动工艺确保了托盘振荡均匀、稳定;
无刷直流电机具有不发热特性,使摇床在振荡时对培养环境的影响降低;


 400-063-6038
400-063-6038
